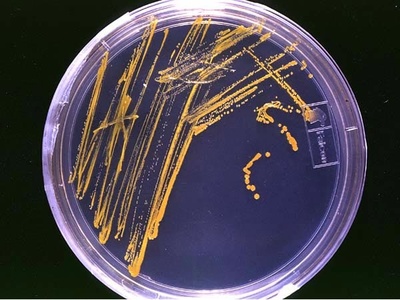
Microbiology

From backyard gardens to metropolitan planning offices, the ways we study the world influence what gets grown, built, or cured. Thinking about science as a landscape helps you see connections between everyday problems and the methods used to solve them.
There are 54 Types of Science, ranging from Agricultural Science to Urban Studies. For each entry you’ll find below the columns Branch, Main topics (max 15 words), Typical applications (max 15 words) so you can quickly scan focus and use cases — you’ll find below a concise, sortable list to explore.
How should I read this list to find fields relevant to my interests?
Scan the Branch column to identify broad areas, then check Main topics for specific subjects and Typical applications to see real-world uses; this three-column setup helps you match your interests or career goals to practical directions without wading through long descriptions.
Can one field span multiple branches or applications?
Yes—many disciplines overlap (for example, environmental issues touch biology, chemistry, and policy), so use the Main topics and Typical applications to spot interdisciplinary links and follow up with more detailed sources for programs or job roles.
Types of Science
| Name | Branch | Main topics (max 15 words) | Typical applications (max 15 words) |
|---|---|---|---|
| Physics | Natural | Matter, energy, forces, motion, quantum, relativity | Electronics, energy, materials, aerospace, research |
| Chemistry | Natural | Atoms, molecules, reactions, bonding, thermodynamics | Pharmaceuticals, materials, chemical manufacturing, energy |
| Biology | Natural | Life, cells, organisms, ecology, evolution | Healthcare, biotechnology, conservation, agriculture |
| Mathematics | Formal | Numbers, structures, proofs, algebra, calculus | Modeling, cryptography, finance, engineering, data analysis |
| Statistics | Formal | Probability, inference, modeling, hypothesis testing | Data analysis, clinical trials, market research, policy |
| Computer Science | Formal | Algorithms, computation, software, data structures, theory | Software, AI, networks, cybersecurity, systems design |
| Astronomy | Natural | Stars, planets, galaxies, cosmology, astrophysics | Space exploration, telescopes, planetary science, education |
| Astrophysics | Natural | Stellar physics, cosmology, high-energy phenomena | Space science, instrumentation, theoretical modeling |
| Geology | Natural | Rocks, minerals, Earth structure, tectonics, geologic history | Resource exploration, hazards, construction, environmental assessment |
| Geophysics | Interdisciplinary | Earth interior, seismic waves, gravity, magnetism | Oil and gas, earthquakes, mineral exploration, geotechnical |
| Meteorology | Natural | Atmospheric processes, weather, climate dynamics | Weather forecasting, aviation, agriculture, disaster planning |
| Oceanography | Natural | Marine ecosystems, currents, chemistry, geology | Fisheries, climate studies, offshore engineering, conservation |
| Ecology | Natural | Organisms, ecosystems, interactions, biodiversity | Conservation, land management, restoration, policy |
| Environmental Science | Interdisciplinary | Pollution, ecosystems, resource management, sustainability | Policy, remediation, conservation, environmental assessment |
| Paleontology | Natural | Fossils, evolution, ancient ecosystems, extinction | Evolutionary studies, geology, museums, education |
| Genetics | Natural | Genes, heredity, DNA, inheritance, variation | Medical genetics, agriculture, biotechnology, forensics |
| Microbiology | Natural | Microbes, bacteria, viruses, fungi, microbial ecology | Medicine, industry, food safety, biotechnology |
| Cell Biology | Natural | Cell structure, organelles, signaling, division | Biomedical research, drug development, cancer research |
| Molecular Biology | Natural | DNA, RNA, proteins, gene expression, regulation | Genetic engineering, diagnostics, biotechnology, research |
| Biochemistry | Interdisciplinary | Biomolecules, metabolism, enzymes, molecular pathways | Pharmaceuticals, diagnostics, biotechnology, food science |
| Neuroscience | Natural | Brain, neurons, cognition, neural circuits | Medicine, psychology, AI inspiration, rehabilitation |
| Psychology | Social | Behavior, cognition, emotion, development | Clinical therapy, education, workplace, marketing |
| Sociology | Social | Societies, institutions, social behavior, inequality | Policy, social services, community planning, research |
| Anthropology | Social | Human evolution, cultures, archaeology, social norms | Cultural preservation, development, museums, policy |
| Archaeology | Social | Material culture, excavation, dating, past societies | Heritage management, museums, historical reconstruction |
| Economics | Social | Markets, incentives, macro/microeconomics, resource allocation | Policy, finance, business strategy, development programs |
| Political Science | Social | Governance, institutions, public policy, political behavior | Policy analysis, government, international relations, NGOs |
| Human Geography | Social | Spatial distributions, populations, urbanization, environment | Urban planning, GIS, transport, resource management |
| Linguistics | Social | Language structure, syntax, semantics, phonetics, pragmatics | Translation, education, NLP, speech therapy |
| Education Science | Social | Learning, pedagogy, assessment, development | Curriculum design, policy, educational technology, training |
| Mathematical Biology | Interdisciplinary | Modeling biological systems, population dynamics | Epidemiology, ecology, systems biology, drug modeling |
| Biophysics | Interdisciplinary | Physical principles in biology, molecular dynamics, imaging | Structural biology, medical imaging, biomaterials, research |
| Bioinformatics | Interdisciplinary | Genomic data, algorithms, sequence analysis | Genomics, personalized medicine, evolutionary studies, biotech |
| Cognitive Science | Interdisciplinary | Mind, cognition, perception, language, AI | Human–computer interaction, AI, education, rehabilitation |
| Systems Biology | Interdisciplinary | Complex biological networks, modeling, omics integration | Drug discovery, biomarker identification, synthetic biology |
| Materials Science | Applied | Structure–property relationships, composites, nanomaterials | Electronics, aerospace, biomedical devices, energy storage |
| Chemical Engineering | Applied | Process design, reaction engineering, transport phenomena | Petrochemicals, pharmaceuticals, materials, food processing |
| Mechanical Engineering | Applied | Mechanics, dynamics, thermodynamics, design | Automotive, aerospace, robotics, manufacturing |
| Electrical Engineering | Applied | Circuits, electromagnetism, signal processing | Electronics, telecommunications, power systems, control |
| Civil Engineering | Applied | Structures, geotechnics, transport, hydraulics | Infrastructure, buildings, bridges, water systems, urban planning |
| Environmental Engineering | Applied | Pollution control, water treatment, remediation | Wastewater treatment, air quality, remediation, compliance |
| Materials Chemistry | Interdisciplinary | Synthesis, properties, chemical structure of materials | Batteries, catalysts, coatings, nanotechnology |
| Pharmacology | Natural | Drug action, receptors, pharmacokinetics, toxicology | Drug development, therapeutics, clinical research, safety |
| Public Health | Applied | Epidemiology, health policy, prevention, health systems | Disease prevention, policy, community health, surveillance |
| Epidemiology | Social | Disease distribution, risk factors, study design | Outbreak investigation, public health policy, clinical research |
| Agricultural Science | Applied | Crop production, soils, agronomy, plant breeding | Farming, food security, crop improvement, sustainable agriculture |
| Food Science | Applied | Food chemistry, safety, processing, preservation | Product development, quality control, food safety, packaging |
| Conservation Biology | Interdisciplinary | Biodiversity, habitat loss, species recovery | Protected areas, restoration, policy, conservation planning |
| Hydrology | Natural | Water cycle, surface and groundwater, runoff, aquifers | Water resources, flood control, irrigation, environmental assessment |
| Soil Science | Natural | Soil properties, fertility, horizons, biogeochemistry | Agriculture, land management, remediation, ecosystem health |
| Geochemistry | Interdisciplinary | Element cycles, isotope geochemistry, mineral chemistry | Resource exploration, environmental monitoring, climate proxies |
| Optics | Natural | Light, wave propagation, imaging, photonics | Telescopes, microscopes, communications, lasers |
| Statistics in Data Science | Formal | Inference, models, uncertainty quantification | Analytics, machine learning validation, business intelligence |
| Urban Studies | Interdisciplinary | Cities, planning, social dynamics, infrastructure | Urban planning, policy, housing, transport design |
Images and Descriptions

Physics
Physics studies fundamental properties of matter and energy, from subatomic particles to the cosmos. It explains forces, motion, and interactions, underpinning technologies like semiconductors, power generation, and instruments, and providing foundational laws used across natural and applied sciences.

Chemistry
Chemistry examines substances, their composition, reactions, and properties at molecular and atomic levels. It explains how matter transforms, enabling drug development, manufacturing, materials design, and environmental monitoring, sitting between physics and biology in many applications.

Biology
Biology investigates living organisms, from molecules and cells to ecosystems and evolution. It seeks to understand growth, reproduction, behavior, and interactions, supporting medicine, agriculture, conservation, and biotechnology innovations that address health and environmental challenges.

Mathematics
Mathematics develops abstract systems, proofs, and quantitative tools to describe patterns and relationships. It provides rigorous foundations for modeling, computation, and analysis across sciences and industry, enabling precise reasoning and technologies like encryption and optimization.

Statistics
Statistics focuses on collecting, analyzing, and interpreting data under uncertainty. It provides methods for inference, experimental design, and prediction used in science, medicine, business, and government to make evidence-based decisions from noisy information.

Computer Science
Computer science studies computation, algorithms, and information processing, from theoretical models to practical software systems. It drives modern computing technologies, artificial intelligence, and networking, shaping how data and automation transform science, business, and daily life.

Astronomy
Astronomy studies celestial objects and the universe’s structure and evolution. It uses observation and theory to understand stars, planets, galaxies, and cosmology, informing space missions, astrophysical models, and our understanding of space-time and cosmic origins.

Astrophysics
Astrophysics applies physics to astronomical objects, explaining processes like nuclear fusion, black holes, and cosmic evolution. It combines observation and theory to probe extreme environments, contributing to instrumentation and fundamental physics discoveries.

Geology
Geology examines Earth’s physical structure, history, and processes such as plate tectonics, volcanism, and erosion. It informs natural resource discovery, hazard assessment, land-use planning, and environmental remediation by interpreting rock records and surface processes.

Geophysics
Geophysics applies physics to study Earth’s interior and physical properties using seismic, gravity, and magnetic data. It supports earthquake analysis, resource exploration, environmental surveys, and engineering by revealing subsurface structures and dynamics.

Meteorology
Meteorology studies the atmosphere and weather processes, using observations and models to predict short-term weather and understand atmospheric phenomena. It supports forecasting, hazard warnings, agriculture, and transportation planning.

Oceanography
Oceanography explores the physical, chemical, biological, and geological aspects of the ocean. It informs climate research, fisheries management, coastal engineering, and marine conservation by studying currents, chemistry, seabed processes, and marine life.

Ecology
Ecology investigates relationships among organisms and their environments, from populations to ecosystems. It guides conservation planning, habitat restoration, and resource management by revealing how species interact, respond to change, and sustain ecosystem services.

Environmental Science
Environmental science integrates biology, chemistry, geology, and policy to study human impacts on natural systems. It assesses pollution, resource use, and sustainability, informing regulation, remediation, and conservation actions to protect human and ecological health.

Paleontology
Paleontology studies ancient life through fossils to reconstruct evolutionary history and past environments. It combines biology and geology to track lineage changes, extinction events, and Earth’s biotic shifts, informing evolutionary theory and stratigraphic correlations.

Genetics
Genetics examines heredity and variation at gene and genome levels, explaining trait transmission and molecular mechanisms. It underpins genetic testing, breeding programs, biotechnology, and understanding disease mechanisms.
Microbiology
Microbiology studies microscopic life including bacteria, viruses, and fungi, exploring their roles in health, disease, and ecosystems. Applications include antibiotics, fermentation, pathogen control, and biotechnological production.

Cell Biology
Cell biology focuses on cellular organization, function, and processes like signaling and division. It is central to understanding disease, developmental biology, and therapies, informing drug targets and laboratory models.

Molecular Biology
Molecular biology examines molecular mechanisms inside cells, such as transcription and translation. It enables genetic manipulation, diagnostics, and biotechnology by revealing how genes are expressed and regulated.

Biochemistry
Biochemistry studies chemical processes within living organisms, focusing on proteins, lipids, carbohydrates, and metabolism. It bridges chemistry and biology to inform drug discovery, clinical diagnostics, and industrial bioprocesses.

Neuroscience
Neuroscience investigates nervous system structure and function from molecules to behavior. It explores perception, learning, and disorders, informing clinical neurology, psychiatry, brain–computer interfaces, and cognitive models.

Psychology
Psychology studies mind and behavior across individuals and groups, examining perception, cognition, emotion, and development. It applies to mental health treatment, education, organizational behavior, and understanding human decision-making.

Sociology
Sociology analyzes social structures, institutions, and group behaviors, focusing on inequality, culture, and organization. Its insights guide public policy, community programs, and social research addressing collective problems.

Anthropology
Anthropology explores human diversity across cultures and time, studying anthropology, archaeology, linguistic patterns, and social practices. It informs cultural heritage, development programs, and understanding of human behavior and social evolution.

Archaeology
Archaeology studies past human societies through material remains and sites. It reconstructs cultural practices, technologies, and social organization, contributing to heritage preservation, historical knowledge, and human origins studies.

Economics
Economics analyzes how scarce resources are allocated, modeling markets, consumer behavior, and macroeconomic trends. It informs fiscal and monetary policy, business decisions, and development strategies to improve welfare and efficiency.

Political Science
Political science investigates political systems, institutions, public policy, and political behavior. It supports governance reforms, electoral analysis, policy development, and international relations understanding.

Human Geography
Human geography studies spatial aspects of human activity, including population, urbanization, and cultural landscapes. It guides urban planning, transportation, resource allocation, and geographic information system (GIS) applications.

Linguistics
Linguistics examines language structure, acquisition, and use, from sounds to meaning. It informs language teaching, AI natural language processing, translation, and understanding cognitive and social aspects of communication.

Education Science
Education science studies how people learn and how teaching methods impact outcomes. It evaluates pedagogies, assessment strategies, and learning technologies to improve educational systems and student achievement.

Mathematical Biology
Mathematical biology applies mathematical models to biological problems, such as population dynamics, disease spread, and biochemical networks. It provides quantitative predictions used in epidemiology, ecology, and systems-level biomedical research.

Biophysics
Biophysics uses physical methods to study biological systems, from molecular mechanics to cellular imaging. It explains structure–function relationships and contributes to techniques like cryo-EM and medical imaging instrumentation.

Bioinformatics
Bioinformatics combines biology, computer science, and statistics to analyze biological data such as genomes and proteins. It enables comparative genomics, personalized medicine, and large-scale biological data interpretation.

Cognitive Science
Cognitive science studies intelligence and mental processes by integrating psychology, neuroscience, linguistics, and computer modeling. It informs AI development, learning strategies, and therapies for cognitive disorders.

Systems Biology
Systems biology examines biological systems as integrated networks using computational and experimental methods. It aims to predict emergent behavior and design interventions in medicine and biotechnology.

Materials Science
Materials science investigates relationships between structure, properties, and processing of materials. It develops new materials for electronics, energy, medical implants, and structural applications, bridging physics, chemistry, and engineering.

Chemical Engineering
Chemical engineering applies chemistry and physics principles to design processes that transform raw materials into valuable products. It underlies chemical manufacturing, pharmaceuticals, energy processes, and scale-up of laboratory reactions.

Mechanical Engineering
Mechanical engineering focuses on mechanics, thermodynamics, and machine design to develop engines, vehicles, and mechanical systems. It drives manufacturing, robotics, HVAC, and transport technologies.

Electrical Engineering
Electrical engineering studies electricity, electronics, and signal processing to design circuits, power systems, and communication networks essential to modern electronics, renewable energy systems, and automation.

Civil Engineering
Civil engineering designs and builds infrastructure like roads, bridges, and water systems. It combines materials understanding, structural analysis, and site assessment to support safe, sustainable built environments.

Environmental Engineering
Environmental engineering uses engineering and science to prevent and remediate pollution, design water and waste systems, and ensure environmental compliance, protecting public health and ecosystems.

Materials Chemistry
Materials chemistry focuses on chemical synthesis and properties of materials, developing functional materials for energy storage, catalysis, and nanotechnology by combining chemical insight with materials engineering.

Pharmacology
Pharmacology studies how drugs interact with biological systems, exploring mechanisms, dosing, and toxicity. It informs rational drug design, clinical trials, and safe therapeutic use in medicine and biotech.

Public Health
Public health focuses on protecting and improving population health through disease prevention, epidemiology, health education, and policy. It directs vaccination campaigns, health surveillance, and community interventions to reduce disease burden.

Epidemiology
Epidemiology studies patterns and causes of disease in populations, using observational and experimental methods to identify risk factors and evaluate interventions for public health decision-making and clinical guidance.

Agricultural Science
Agricultural science studies crop and livestock production, soil management, and breeding to increase yield, sustainability, and resilience, supporting food systems, agribusiness, and rural development.

Food Science
Food science examines the chemistry, microbiology, and engineering of food, improving safety, nutrition, shelf life, and product development for the food industry and public health.

Conservation Biology
Conservation biology applies ecological principles to preserve biodiversity, manage endangered species, and restore habitats. It informs conservation strategies, policy-making, and practical actions to maintain ecosystems and their functions.

Hydrology
Hydrology studies movement and distribution of water on Earth, informing water resource management, flood prediction, irrigation planning, and contamination mitigation to ensure sustainable water supplies.

Soil Science
Soil science examines soil formation, structure, nutrients, and organisms to inform agriculture, land-use decisions, and environmental remediation, playing a central role in food production and ecosystem services.

Geochemistry
Geochemistry studies chemical composition and processes of Earth materials, tracking element cycles and using isotopes to date rocks, trace pollution, and reconstruct past climates.

Optics
Optics studies light behavior, imaging, and photonics with applications in microscopy, telecommunications, medical devices, and laser technologies, affecting science, industry, and everyday imaging systems.

Statistics in Data Science
Statistics in data science adapts statistical inference for large, complex datasets, emphasizing robust modeling, uncertainty quantification, and validation to support reliable data-driven decisions across industries.

Urban Studies
Urban studies analyze cities as complex social and physical systems, examining urban form, inequality, and infrastructure to guide planning, housing policy, transportation, and sustainable urban development.

